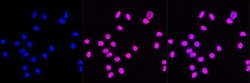
Invitrogen CHK2 Recombinant Rabbit Monoclonal Antibody (23GB3460), Invitrogen

missing translation for 'onlineSavingsMsg'
Learn More
Learn More
Invitrogen™ CHK2 Recombinant Rabbit Monoclonal Antibody (23GB3460), Invitrogen™
Rabbit Recombinant Monoclonal Antibody
Brand: Invitrogen™ MA553361
This item is not returnable.
View return policy
Description
CHEK2 (CHK2) is a serine/threonine kinase and a component of the DNA damage checkpoint pathway. A mutation in CHK2 has been linked to cancer. CHK2 is activated by DNA damage and phosphorylates several modulators of cell cycle control including tumor suppressor proteins. In addition, Chk2 can phosphorylate BRCA1, allowing BRCA1 to restore survival after DNA damage. Chk2 is a putative tumor suppressor protein, with mutations in to the Chk2 gene linked to Li-Fraumeni syndrome, a familiar cancer usually associated with inherited mutations in TP53. Also, mutations in CHK2 are thought to confer a predisposition to sarcomas, breast cancer, and brain tumors.
Specifications
| CHK2 | |
| Recombinant Monoclonal | |
| Unconjugated | |
| Chek2 | |
| CDS1; cds1 homolog; Checkpoint kinase 2; Checkpoint like protein CHK2; checkpoint-like protein CHK2; Chek2; Chk2; Chk2 (phospho T68); Chk2 (pThr68); CHK2 checkpoint homolog; CHK2 checkpoint homolog (S. pombe); Chk2 phospho; Chk2 phospho T68; del9; EC 2.7.11.1; hCds1; HuCds 1; HuCds1; kinase Chk2; LFS2; OTTHUMP00000199044; OTTHUMP00000199045; OTTHUMP00000199064; OTTHUMP00000199115; OTTHUMP00000199116; phospho Chk2 (T68); phospho Thr68 Chk2; PP1425; protein kinase Chk2; Rad53; Rad53 homolog; RP11-436C9.1; Serine/threonine protein kinase Chk2; serine/threonine-protein kinase Chk2 | |
| Rabbit | |
| Affinity chromatography | |
| RUO | |
| 11200 | |
| -20°C | |
| Liquid |
| Flow Cytometry, Western Blot, Immunocytochemistry | |
| 23GB3460 | |
| PBS with 50% glycerol and 0.02% sodium azide; pH 7.4 | |
| O96017 | |
| Chek2 | |
| A synthetic peptide of human Chk2 (30-180AA). | |
| 20 μL | |
| Primary | |
| Human | |
| Antibody | |
| IgG |
Product Content Correction
Your input is important to us. Please complete this form to provide feedback related to the content on this product.
Product Title
Spot an opportunity for improvement?Share a Content Correction